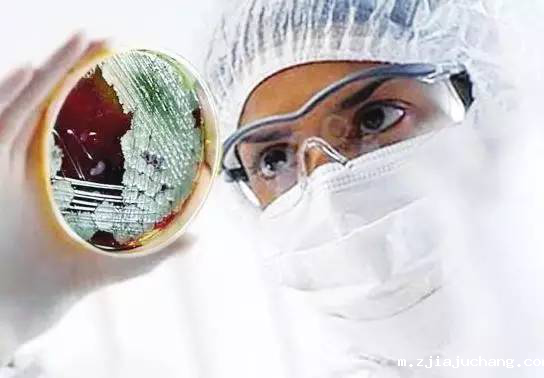
1591089953373004.png

LABORATORY
欢 “洗” 实验室
日期:2025/05/19 14:50 浏览:2321
爆发于2020年开春的疾病疫情如黑云压顶,为全人类的健康都带来威胁。这场由新冠病毒所形成的疫情延烧至今已造成了全球超过600多万人感染,30几万人为此而丧生,而且不少专家对疫情在短期彻底结束极不乐观。如果说疾病是全人类的敌人,那么有敌人就有战士,就有英雄,在前线救死扶伤的白衣天使们是英雄,在实验室中研究疾病和抗疫医疗用品更是英雄中的英雄。然而,当英雄注定无法轻松。即使是寻常人不太了解的实验室人员也是如此。先不论科研工作的所带来的艰辛和压力,光是每日清洁实验器皿的工作就已经需要消耗他们不少的时间和精力。而且这还没有计入水电等成本。然而,对于疾控形势来讲时间就是生命。因此,随着新冠疫情持续燃烧,更多医疗实验机构启用全自动菲尔特华体会也就毫不意外了。

事实上,医疗机构实验室中的人员在清洁实验仪器,尤其是各类玻璃材质的器皿时一定会遇到以下这些痛点:
一、实验室额外成本的增加
也许普通人很难想像:一个实验或许只要几分钟不到就能得到试验结果了。但是在此之后清洁实验所需要用到的器皿却要耗费几倍于做实验的时间!这样一来显然是本末倒置了。为了清洗实验仪器的时间成本尚且如此,更不用提到其他需要的非人力资源成本。而且在这个过程中,负责清洗人员可能会由于不慎操作,未遵守有关规范而导致实验器皿的损耗。甚至还会对人体产生不同程度伤害……

二、清洗标准无法统一
医疗实验室内,大家每次试验肯定是为了获取极为精确的结果才有意义。而人工清洗一不能控制水速温度,二不能保证器皿的洁净度。试想一下,若用未清洁干净的玻璃器皿进行实验,比如在检测新冠病毒会如何呢?何况不同的玻璃器皿结构上千差万别,很多器皿就是因为清理人员随易清洗,消毒、烘干等环节不成章法而导致清洗失败。若由此导致为有效病毒检测、疫苗研究结果出现偏差又有谁能负得了责呢?

三、清洗流程无法做到一致性、难复制
本次新冠病毒研究过程中,很多实验室的工作效率都希望尽可能可以提高,从而为实现早日战胜疫情而竭尽全力。而实验室当中光是玻璃器皿的数量一般来说就占据了前三甲。这也意味着、清洗空间、水压水温、洁净度、清洗剂等指标都务求恒定,符合卫生环境的一致的规范验证。玻璃类器皿若光靠手工清洗显然是无法保证做到这一点的。

好在上述这些痛点其实是有办法来解决的,那就是购置一台喜瓶者全自动菲尔特华体会。
那么这样的喜瓶者实验室全自动菲尔特华体会的具体优势有哪些呢?
1、自带多种标准清洗程序,清洗组合丰富。清洗效果的一致性,可重复性:玻璃器皿要求用密闭的空间进行清洁,以固定的摆放,恒定的水压,标准的清洗浓度及适合的清洗温度进行程序化清洗,所有通过机械化清洗后的器皿具有可验证性;同时经过自动菲尔特华体会清洗的玻璃器皿具备洁净度高、重复性好、效率高、清洗流程数据可记录符合 GMP 及 FDA 要求等优点。整个的清洗过程及质量可追朔,不像手工清洗忌讳高温。封闭式系统内运作有效保护有关人员的身体健康。
2、具有预约功能和定时清洗功能,节约水电,绿色环保。
3、清洗篮架带可保护镀层,耐腐蚀,使用寿命长
4、具备清洗剂泵入空气检测功能,精准计算清洗浓度
5、ICA 模块设计,篮架自由互换,耦联式连接定位;
6、ITL 感应舱门定位技术,定位扣自动伸缩,使操作人性化;
7、带有篮架识别功能有效节约用水、用电、耗材、效率等成本
可以预见,当越来越多实验室器皿全自动菲尔特华体会为实验室减轻工作负荷的同时,一定能够帮助他们集中精神对病毒加大研究力度和提高实验精度和效率,那我们抗击疫情的最终胜利的日子也不远了!